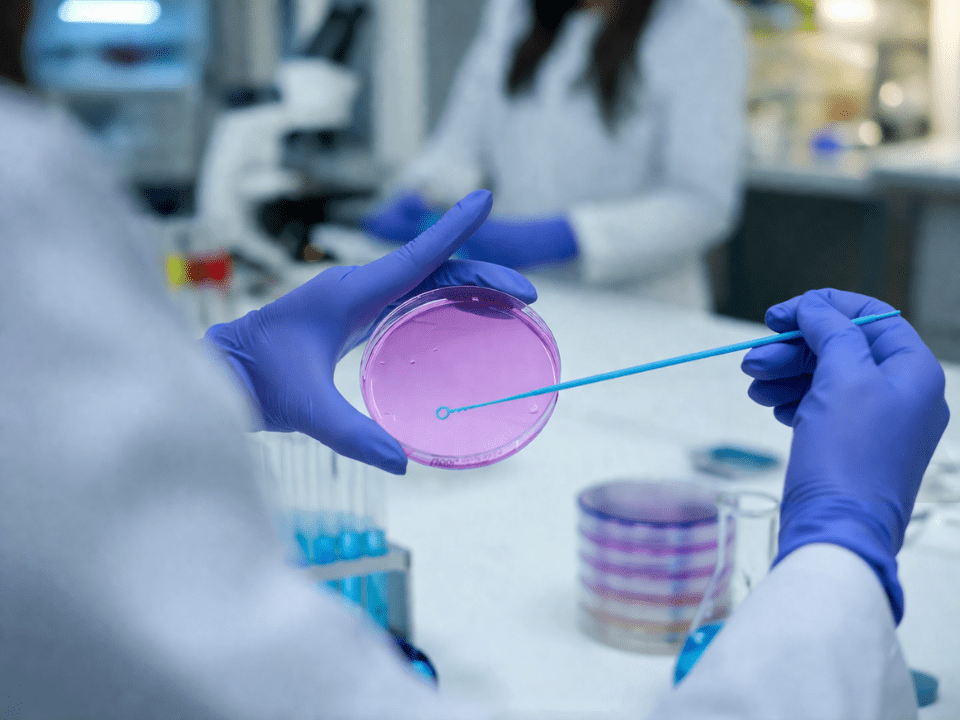
Profissional de laboratório com luvas nitrílicas azuis manipulando placa de Petri com meio de cultura rosado, utilizando alça de inoculação, em ambiente laboratorial moderno com fundo desfocado, representando análise microbiológica e cultivo bacteriano.

Uma abordagem baseada em cultivo amplo seguido de sequenciamento genômico demonstrou capacidade de mapear áreas críticas de disseminação bacteriana em unidades de terapia intensiva (UTI). O método, mais acessível que estratégias metagenômicas tradicionais, oferece uma alternativa viável para vigilância ambiental contínua em ambientes hospitalares.
A vigilância microbiológica ambiental em hospitais ainda enfrenta limitações operacionais e de custo, especialmente quando se busca alta resolução genômica. Um estudo recente publicado no periódico Microbial Genomics avaliou uma estratégia baseada em “plate sweeps”, combinando cultivo não seletivo com sequenciamento, para monitorar a dinâmica bacteriana em uma unidade de terapia intensiva.
A pesquisa foi conduzida em uma UTI privada recém-inaugurada na Austrália, com oito leitos, ao longo de quatro meses. Foram coletadas amostras de 78 pontos distintos da unidade, antes e após a admissão dos primeiros pacientes, permitindo comparar a microbiota ambiental em dois cenários operacionais.
O fluxo metodológico adotado foi direto e aplicável à rotina laboratorial. Após coleta por swab, as amostras foram cultivadas em meio não seletivo. Em seguida, todo o crescimento microbiano foi recuperado das placas, processado para extração de DNA e submetido ao sequenciamento em plataforma Illumina. A análise bioinformática incluiu identificação taxonômica e detecção de genes de resistência antimicrobiana.
Os resultados indicaram uma mudança substancial na composição bacteriana após o início da ocupação da unidade. Embora a taxa de crescimento positivo tenha permanecido estável, houve uma reconfiguração relevante do microbioma ambiental. Apenas três dos 22 gêneros identificados estavam presentes em ambos os períodos.
Na avaliação pós-ocupação, observou-se aumento na diversidade bacteriana e maior presença de genes associados à resistência antimicrobiana, incluindo marcadores relacionados a beta-lactâmicos, quinolonas e fosfomicina. Entre os gêneros predominantes estavam Pseudomonas, Delftia e Stenotrophomonas, frequentemente associados a ambientes hospitalares e a infecções oportunistas.
A análise de transmissão revelou 17 possíveis conexões entre diferentes pontos amostrados em um único momento. Áreas relacionadas à infraestrutura hidráulica, especialmente banheiros compartilhados, emergiram como focos relevantes de disseminação bacteriana. Esse achado reforça o papel de superfícies úmidas e sistemas de encanamento como reservatórios persistentes de microrganismos em ambiente hospitalar.
Implicações para o diagnóstico e controle de infecção
Do ponto de vista da medicina diagnóstica, o estudo amplia o papel do laboratório na vigilância ambiental. A abordagem de plate sweeps permite capturar uma diversidade microbiana maior do que métodos baseados em isolamento de colônias individuais, sem o custo elevado de análises metagenômicas profundas.
Na prática, isso viabiliza programas de monitoramento mais frequentes e direcionados, com potencial para identificar precocemente áreas de risco e orientar intervenções em limpeza, desinfecção e infraestrutura hospitalar.
Além disso, a detecção de genes de resistência diretamente no ambiente oferece uma camada adicional de informação para estratégias de controle de infecção, antecipando cenários de risco antes da manifestação clínica em pacientes.
Referências
Instituição: Queensland University of Technology, em colaboração com University of Southern Queensland, The University of Queensland e St Vincent’s Private Hospital Toowoomba
Periódico: Microbial Genomics
Autores principais: Aasha McMurray-Jones, Leah W. Roberts e colaboradores